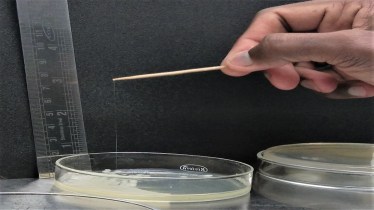
IIT Jodhpur, IIT scientists, infections, health news, healthcare news,

A team of scientists at the Indian Institute of Technology, Jodhpur led by Dr. Shankar Manoharan, Assistant Professor, Department of Bioscience & Bioengineering, have found the possible reason of behind the virulence and antibiotic resistance of Klebsiella pneumoniae bacteria.
According to a press statement, the studies conducted in collaboration with scientists from the All India Institute of Medical Sciences, AIIMS Jodhpur and Vellore Institute of Technology, VIT Vellore, use genomics and molecular biology approaches to identify new genes responsible for the bacteria’s potency.
According to reports, Klebsiella pneumoniae is one of the pathogens on the World Health Organisation’s priority list and is a significant cause of hospital-acquired diseases such as pneumonia, bloodstream infections, and infections among ICU patients and newborns.
ALSO READ | IIT Guwahati establishes biomedical device and diagnostic centre for health tech facilities in rural India
Reportedly, the management and treatment of Klebsiella pneumoniae have challenged the medical and scientific community across the world due to its high virulence and antibiotic resistance. Meanwhile, the findings of this research have been published recently in the journal, Microbiology Spectrum.
“One of the ways in which Klebsiella pneumoniae escapes the body’s immune system, and antibiotics is by producing an extremely sticky and viscous protective covering (hypermucoviscosity) around itself,” Dr. Shankar Manoharan, Assistant Professor, Department of Bioscience and Bioengineering, IIT Jodhpur, said in a statement on Monday.
The team of researchers tested the hypermucoviscosity using the string test, in which a bacterial colony growing in laboratory media is touched using an applicator, which is then slowly lifted off the colony.
“If a sticky string of 5 mm or more excellent extends from the colony to the applicator, the bacteria is hypermucoviscous and highly virulent. The researchers studied a strain of the bacteria called P34, isolated from the cystic lesion of a patient at a tertiary care hospital in Jodhpur and found that it produced a string of 65 mm long,” the scientists said in a statement.
The scientists are currently studying the mutants and disrupted genes of the bacteria and they are hopeful that the outcomes with help in developing ways to effectively control the spread of such strains and treat infections caused by them.